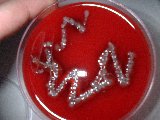

Waar kan ik met mijn zieke-vis naar toe??
(Prijzen onder voorbehoud)
UPDATE 03-01-2008

Omdat ik zelf ook met vissen kweek en importeer, heb je de kans dat ze ziek kunnen worden net als ieder ander dier. Daarnaast gebeurt het wel eens als vissen rechtstreeks van vijvers afkomen zoals bv bij Japan, dat deze wel eens parasieten en of bacteriën kunnen meedragen? En dan...
Omdat de meeste dierenartsen weinig tot geen kennis hebben van visziekten, ben ik er zelf in gaan verdiepen. Dit komt ook helaas omdat het momenteel in Nederland nog niet mogelijk is om een volledige opleiding visarts te volgen. Wel worden er een aantal cursussen /studie gegeven over o.a. visteelt en ook een cursus over ziekten bij vissen van oa CIDC-Lelystad waar dierenartsen die zich willen verdiepen op het gebied van visziekten aan mee kunnen doen. Waar ik zelf ook aan heb deelgenomen. Deze cursussen waren natuurlijk niet voldoende om in de praktijk fatsoenlijk aan de slag te gaan. Maar omdat ik toen studeerde heb ik bij diverse winkels, importeurs en groothandels op het gebied van siervissen stage kunnen lopen om bij hen praktijkervaring op te doen. Daarnaast probeer ik zoveel mogelijk kennis te vergaren uit de internationale maar ook nationale (want de bevindingen hier in Nederland zijn eigenlijk nog belangrijker) wetenschappelijke literatuur en onderhoud ik kontakten met importeurs en exporteurs in binnen en buitenland. Maar ook ben ik fulltime aan het werk in deze branche, hierdoor ben ik continu bezig met de gezondheid van vissen.
Omdat het vaak moeilijk is om iemand te vinden met kennis is op het gebied van visziekten is er een mogelijkheid om een afspraak te maken met mij.

Wat kan ik u bieden?
- Huisbezoek of u komt met de vis naar mij toe
- Parasitair onderzoek met de microscoop en advies voor de juiste behandeling hiertegen.
Om te weten wat de vis heeft? Dient de vis in leven te zijn. Want als de vis dood is, is de mogelijke gastheer ook zo verdwenen of ook gestorven.
- wondbehandeling en ondersteuning met antibioticum
- aankoopkeuringen.
- Onderzoek diverse organen(hiervoor moet de vis open gemaakt worden).
- Afenten voor bacteriologie.

(foto1)een mooi plaatje. (foto2) groei van bacterieen
- Ook is het mogelijk dat de bacterieen worden onderzocht, denk hier aan de typering van de bacterie.
Consult te Veenendaal:
(alleen op afspraak)
De kosten bedragen per consult (ongeveer 15 minuten; inclusief evt. watercontrole): € 10,-.
Wat kost een huisbezoek:
De kosten bedragen € 95,00 per uur gerekend vanaf Veenendaal en € 0,75 rijkosten per kilometer. De minimum voorrijkosten bedragen € 75,-.
Ter verduidelijking een aantal voorbeelden:
Voorbeeld 1: Ede Afstand: 30 km retour € 22,50
Reistijd: 20 minuten € 31,66
De totaalkosten van rijkosten en reistijd is minder dan de minimum voorrijkosten,
er geldt dus: € 75,00
Arbeid ter plaatse: 1 uur € 95,00
Kosten verstrekte middelen: Afhankelijk van situatie € ??,??
Totaal (excl. middelen): € 170,00
Voorbeeld 2: Apeldoorn
Afstand: 76 km retour € 57,00
Reistijd: 45 minuten € 71,25
Arbeid ter plaatse: 1 uur € 95,00
Kosten verstrekte middelen: Afhankelijk van situatie € ??,??
Totaal (excl. middelen): € 223,25
Maar ook kunt u met een zieke vis naar ons toekomen voor onderzoek, en kunt u ook terecht voor diverse medicijnen en advies.

Ook kunt u terecht voor diverse medicijnen en advies.